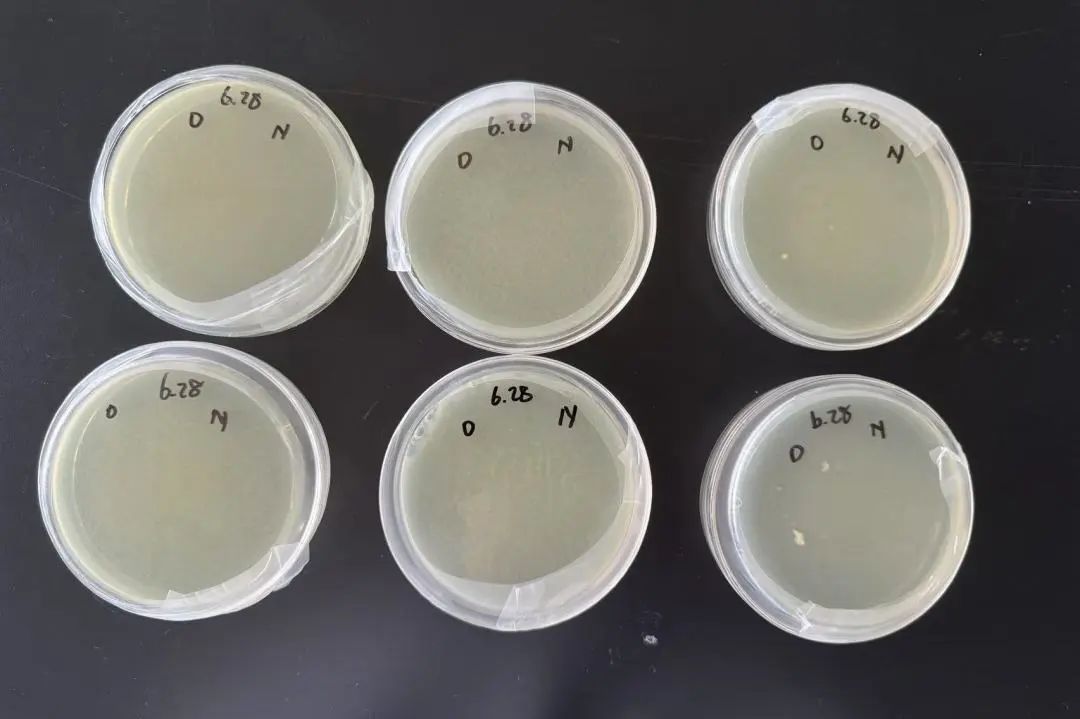

张语桐:奉献、利他、乐群、卓越,她成就自己,也照亮他人 | 新英才毕业生专访(2025)

2010·幼儿园 入读新英才学校
2025·十二年级 获得“特殊贡献奖”
2025·十二年级 伦敦大学学院录取
在新英才学校的校园里,张语桐的名字总是与“优秀”紧密相连。学术上,她斩获数学、生物、化学等主要竞赛的金奖,实现大满贯;学术之外,她虽从不站在聚光灯下,却始终以温暖与真诚照亮他人。
凭借对知识的热忱与对科研的执着,她一路披荆斩棘,收获了伦敦大学学院(University College London, UCL)、伦敦国王学院(King's College London, KCL)以及爱丁堡大学(The University of Edinburgh)等世界顶尖院校自然科学(Natural Sciences)专业的录取通知书。
自幼儿园小班起,她便在新英才扎根成长,完整经历了十五年一贯制教育的浸润与滋养。她的成长轨迹与学术追求,不仅彰显了个人的卓越才华,更映照出新英才学校深厚的教育底蕴。
从兴趣出发
向自然科学而行
PART ONE
张语桐的学术之路,起初并非目标清晰。她在物理、化学、生物等多个学科都表现出色,兴趣广泛,反而让她在选择专业时一度陷入犹豫:“我现在还不能确定一个特别具体的方向,怎么办?”
在与升学指导金顺玉老师深入沟通后,老师建议她选择自然科学专业。这个专业的课程设置相对宽泛,能让她在大学期间继续探索不同的学科领域,再逐步明确自己的研究方向。于是,她在申请伦敦大学学院(UCL)和伦敦国王学院(KCL)时,都选择了自然科学专业。这一选择不仅给了她更多时间去摸索,也让她有机会在更广阔的学术天地中,慢慢找到自己真正的热爱。
在申请爱丁堡大学时,她也尝试做出了一个更具体的选择——生物科学(Biological Science)下的植物学方向。这个决定的背后是一次深刻的触动。那段时间,她在准备个人陈述的过程中观看了不少植物相关的纪录片,镜头下微观世界的精妙与植物生命的韧性深深吸引了她。
张语桐为九年级学生做植物学相关的兴趣分享
“
我发现植物学、环境科学、微生物这些领域其实非常有趣。它们不只是实验室里的研究对象,更是和我们生活、地球未来息息相关的东西。
尽管父母更倾向于她学习商科,但张语桐始终觉得“做生意很无聊”,更愿意追随自己的兴趣。她的坚持不仅源于对未知世界的好奇,也来自对科学领域未来发展的理性判断。
“
其实科学领域的就业机会很多,无论是纯粹的科研,还是科研成果的转化,都有广阔的发展空间。特别是生物学科,契合当下可持续发展的政策导向,未来潜力巨大。
在张语桐看来,自然科学是理解世界的基础学科,也是推动未来科技和社会发展的关键力量。尤其是在工业化浪潮之后,环境与可持续发展成为全球关注的焦点,自然科学和生命科学都正站在时代的风口,回应着人类对未来的关切,前景无限。最终,父母被她的清晰规划和坚定信念所打动,选择尊重并支持她的决定。
十一年级 在金顺玉老师指导下做生物课外研究实验
尽管十年级时,张语桐已经完成了一个关于基因编辑的EPQ拓展研究项目,但为了更贴合后来确定的自然科学专业申请方向,她在十一年级上学期,又在升学指导、生物教师金顺玉老师的指导下,开启了一项全新的苔藓研究课题。
这次,她选择了《角苔蓝藻共生机制研究》作为课题,希望通过深入探索角苔与蓝藻之间的共生关系,寻找减少化肥使用的新途径。在研究过程中,张语桐从论文中发现角苔可以与蓝藻共生,这激发了她浓厚的兴趣。她通过查阅大量文献,梳理出共生过程中表达的基因,并设计程序筛选出角苔特有的基因。她还利用生物信息学网站,分析这些基因在代谢通路中的作用,试图揭示角苔与蓝藻共生的秘密。
张语桐为角苔研究项目构建系统发生树
为了进一步深化研究,在十一年级的暑假,张语桐参加了中国科学院的系统发育相关实习。在实习期间,她学习了生物信息学知识,并将其应用于苔藓研究项目。她从NCBI平台提取了拟南芥和角苔的基因组数据,结合哈佛大学Harvard X Data Science: R Basics网课中学到的数据分析技能,编写了基因比较程序,成功筛选出角苔特有基因。
在后续研究中,她利用DAVID网站对这些基因进行KEGG富集分析,发现角苔在氮素胁迫下,基因RAM1表达显著上调。这一发现让她深入思考蓝藻与植物共生的机制,并设想通过基因编辑技术,让蓝藻为宿主植物提供更多帮助,例如溶解磷元素,从而减少化肥使用。
这段科研经历,不仅让张语桐掌握了扎实的专业知识和实验技能,更坚定了她未来在前往伦敦大学学院,在自然科学领域深入探索的决心。她相信,每一个科研项目的背后,都隐藏着改变世界的力量。
舞台的灯光由她照亮
PART TWO
张语桐不仅是学术上的佼佼者,更是新英才学校各类活动中的中坚力量。她的身影,活跃在舞台的幕后,用责任和担当,点亮了一场又一场精彩的演出。
语桐是个天使一般的孩子,内心豁达,不拘小节,班级里的大事小事她都张罗着去做。任何事情只要告诉她了我就放心了,我觉得我相信她超越了相信自己。
尹桂艳 班主任/数学教师
12A班级合影 尹桂艳老师(左一) 张语桐(后排右三)
张语桐的初中导师、中学六年以来的语文老师范丽老师,是张语桐成长路上的重要引路人。范老师不仅在学术上给予她悉心指导,更在课外活动中为她提供了广阔的舞台。在范老师的鼓励下,张语桐初涉戏剧节后台工作,从灯光调试到音响设备,从导演到统筹,她几乎全能。
在新英才学校丰富的活动中,张语桐的身影无处不在。她负责过结业式、年底大戏、运动会开幕式、剑桥音乐节等舞台活动上,她负责灯光对接,精准把控每一个细节,确保演出顺利进行。从9年级独自一人承担工作,到11年级带领学弟学妹们共同完成任务,她不仅提升了自身能力,更培养了团队协作精神。
十一年级校运动会班级合影 张语桐 (前排左三)
张语桐是一个古道热肠、有担当和大格局的学生,从不在个人得失上斤斤计较,是这个年龄中少有的那种有奉献精神的孩子。
舞台的聚光灯下没有她的身影,她永远是幕后那个奔波忙碌、成就别人的人。她是那个反复推敲并和各个环节沟通的人,把共同合作的同学紧密地组织团结在一起出色完成任务的人。
这是一个非常正能量并有领导力、公信力的学生,她的未来值得期待。
范丽 初中导师/语文教师
张语桐(左二)获得“特殊贡献奖”
组织大型活动,对张语桐而言是挑战更是机遇。她需预判未来可能发生的情况,解决突发事件,同时兼顾时间管理,确保每个环节按时推进。在2023年度大戏《上海屋檐下》的筹备中,她白天写剧本,晚上复习物理大考,常常作业写到凌晨。
张语桐在担任《上海屋檐下》改编及舞台幕后工作
每次情绪低谷时,化学老师杨晓丽老师总会给予她温暖安慰,让她重燃斗志。最终,大戏圆满落幕,她的物理成绩也相当亮眼(127/130)。这段经历让她学会了时间平衡与心态调整,此后面对任何挑战,她都能从容应对。
张语桐(左二)和杨小丽老师(左四)
张语桐的责任心与利他精神,也体现在她对同学的无私帮助上。在紧张的大学申请季,她不仅完成自己的申请文书,还为其他同学出谋划策,从不保留。无论是对同年级处于竞争范围的同学,还是对其它年级单纯求助的同学,她都施以援手。
她常利用课余时间给同学们讲解题目,分享笔记。十二年级大考结束后,她闲不下来,又为十年级学生制作150余页的PPT,涵盖物理、化学、生物、数学及竞赛知识,利用大课间或晚自习为大家授课。
张语桐为十年级学生补习IGCSE物理
在社团活动中,张语桐同样大放异彩。她与同学姚佳钰、翁家骏共同创立生物社团iBio,带领成员做实验、开展小型科研项目,分享前沿技术与知识点。在组织活动的过程中,她不仅加深了自己对理论的理解,更收获了满满的成就感。她坦言:“在举办活动的同时,我自己也复习了知识,还能给大家提供帮助,这让我非常开心。”
在我印象中,张语桐总是在为身边的人提供学业上的帮助。十年级的时候我们一起在班里的学习小组工作,十一年级她的学生范围拓展到了整个年级,后来甚至是整个学部。
每一次作为社长在iBio社团进行知识分享,张语桐都会提前很久备课,仔细筛选、整理内容,十分负责。无论是生物、物理还是数学,她总能清晰地讲解知识点并总结出高效的学习方法。
云朵朵, 张语桐同班同学
伦敦政治经济学院录取
云朵朵(左一)张语桐(左二)和朋友们
新英才学校为怀持着不同兴趣和天赋,并拥有强烈上进心的学生规划了166项国内外竞赛/挑战活动,并提供免费参赛辅导,助力学生在跨学科、多元化的背景下,全面提升综合素质和竞争力,从新英才学校走向世界。张语桐在感兴趣的生物、化学、数学学科竞赛中屡屡斩获金奖,展现出极强的学术实力。
张语桐竞赛获奖情况
BBO 英国生物奥林匹克 金奖
IBO 英国生物测评(中级)金奖
UKChO 英国化学奥林匹克 金奖
C3L6 剑桥化学挑战赛 金奖
SMC 高级数学思维挑战活动 金奖
CCC 加拿大化学竞赛 银奖
张语桐深知,竞赛成绩和课外活动是锦上添花,扎实的成绩才是根基。因此,她不会本末倒置,始终将学业放在首位,同时用活动丰富自己的校园生活,提升综合能力。
学术与活动双轨并行,张语桐成长为一名品学兼优、全面发展的优秀毕业生,成就自己,也照亮他人。
张语桐为剑桥国际中心2025届毕业生制作纪念册
向前走,不问终点
PART THREE
张语桐对未来的想象带着一点不确定的期待。她并不急于给自己的人生定下过于具体的轨迹,而是更愿意在探索中寻找方向。
相比于实验室里的动手操作,张语桐更享受思考的过程——那种在脑海中推演、在逻辑中穿梭的感觉,让她感到真正的自由。在大学里,她希望有机会多和教授交流,不是为了得到明确的答案,而是为了在对话中碰撞出新的想法。在伦敦大学学院完成自然科学课程后,她希望加入感兴趣的科研团队,尝试参与一些理论研究项目。
“
我不太确定自己会不会一直留在实验室,但我确定的是,我会一直保持思考,我喜欢‘动脑子’的感觉。
除了学术,张语桐也希望自己的生活能有一些“非科研”的部分。比如,她计划去植物园实习,不是为了完成某个项目,而是想让自己慢下来,看看植物是怎么生长的、自然是怎么运作的。同时,也可以更好地确认自己在植物学与环境科学方向是否仍有深耕的兴趣。
她还计划和好朋友住在同一幢公寓,在课余好好修炼厨艺。她自嘲自己做饭真的非常难吃,不过她似乎有着“迷之自信”——相信海外留学生活,可以每一个“留子”都变成“厨子”。
张语桐(前排左二)在毕业典礼上
在她面对未知和焦虑的时候,她常常会想起数学老师说过的一句话:“要相信‘相信’的力量。”起初她并不理解这句话的深意,直到有一次她在准备考试和排练戏剧的双重压力下几乎崩溃,老师用这句话安慰她,她才意识到,原来很多时候,真正支撑我们走下去的,不是对结果的掌控,而是对过程的信任。
“
你不能总是控制结果,但你可以选择相信。只要相信事情会好起来,就真的会更有力量去面对它。
张语桐(右)和父亲在毕业典礼上
张语桐的故事,是一段关于探索、坚持与成长的旅程。从幼儿园小班到高中毕业,十五年来,她一步步走过新英才学校的校园,在这里获得了自由探索的空间与坚定前行的底气。她从不站在聚光灯下,却始终以温暖与真诚照亮他人。
如今,她即将启程前往伦敦大学学院,开启一段全新的学术旅程。面对未知,她选择相信;面对选择,她坚持热爱。愿她在更广阔的天地中,继续保持那份真诚与热情,在不确定的世界里,走出属于自己的确定。

- 校园开放日 -
欢迎走进新英才 / 席位有限 / 扫码预约

发表评论